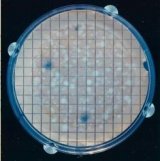

Women of Technology Transfer: Patent Holders

Jessica Murray

Jessica Murray
Center for Public Health and Environmental Assessment (CPHEA)
Dr. Jessica Murray’s work supports testing for the Toxic Substances Control Act to evaluate potential risk of harm by new and existing commercial chemicals; specifically inhalable chemicals such as Volatile Organic Compounds (VOCs) and aerosols. VOCs are present in many household products including paints, glues used in crafting, and cleaning agents. The aerosols or mist in many households come in the form of almost anything that comes out of a spray can. These include products like pesticides, weed killers, or hairspray. VOCs and aerosols are also known for their potential adverse health effects following inhalation exposures. Inhalation concentrations can vary greatly depending on whether a product is used indoors or outdoors. These factors make Jessica’s work more challenging. Additionally, Jessica and her colleagues had limited options to study aerosols under cell culture conditions where crucial factors like relative humidity and concentration levels could be controlled.
Elizabeth Sams

Elizabeth Sams
Office of Research and Development (ORD)
Helping people avoid environmental hazards is an important part of Epidemiology. Finding innovative methods to measure and monitor health is a never-ending quest. Saliva sample collection devices offer an easy-to-use non-invasive tool that collects saliva for various health biomarker analysis. These biomarker measurements provide researchers invaluable data that can be used to monitor population health. Finding an appropriate saliva collection tool can be challenging. In response to this challenge, Elizabeth Sams invented the double-bottom test tube as a simple and low-cost collection tool that reduces processing time and cross-contamination. This test tube can be used for any wet specimen collection.
Wendy Jo Davis-Hoover

Wendy Jo Davis-Hoover (Retired)
Dr. Davis-Hoover’s inventions include numerous soil remediation technologies for cleaning up hazardous waste sites. Her technologies utilize microbes to degrade pollutants.
Dr. Davis-Hoover’s technology utilizing Thermophilic Methanotrophs for high temperature oxidations consists of a group of aerobic microorganisms known as methanotrophs, which have previously been used to degrade organic contaminants.
Kristen Brenner

Kristen Brenner, PhD (Retired)
Dr. Brenner’s patented invention, Method 1604 (MI Medium), is a USEPA-approved membrane filtration method using MI agar or MI broth for the simultaneous detection of two indicator organisms (Total coliforms and Escherichia coli) in drinking water, source water, ground water, and ambient water in 24 hours or less. Indicator organisms demonstrate the possible presence of pathogens (disease-producing microorganisms) in the water. The MI Medium Method can also be used with other types of environmental samples.